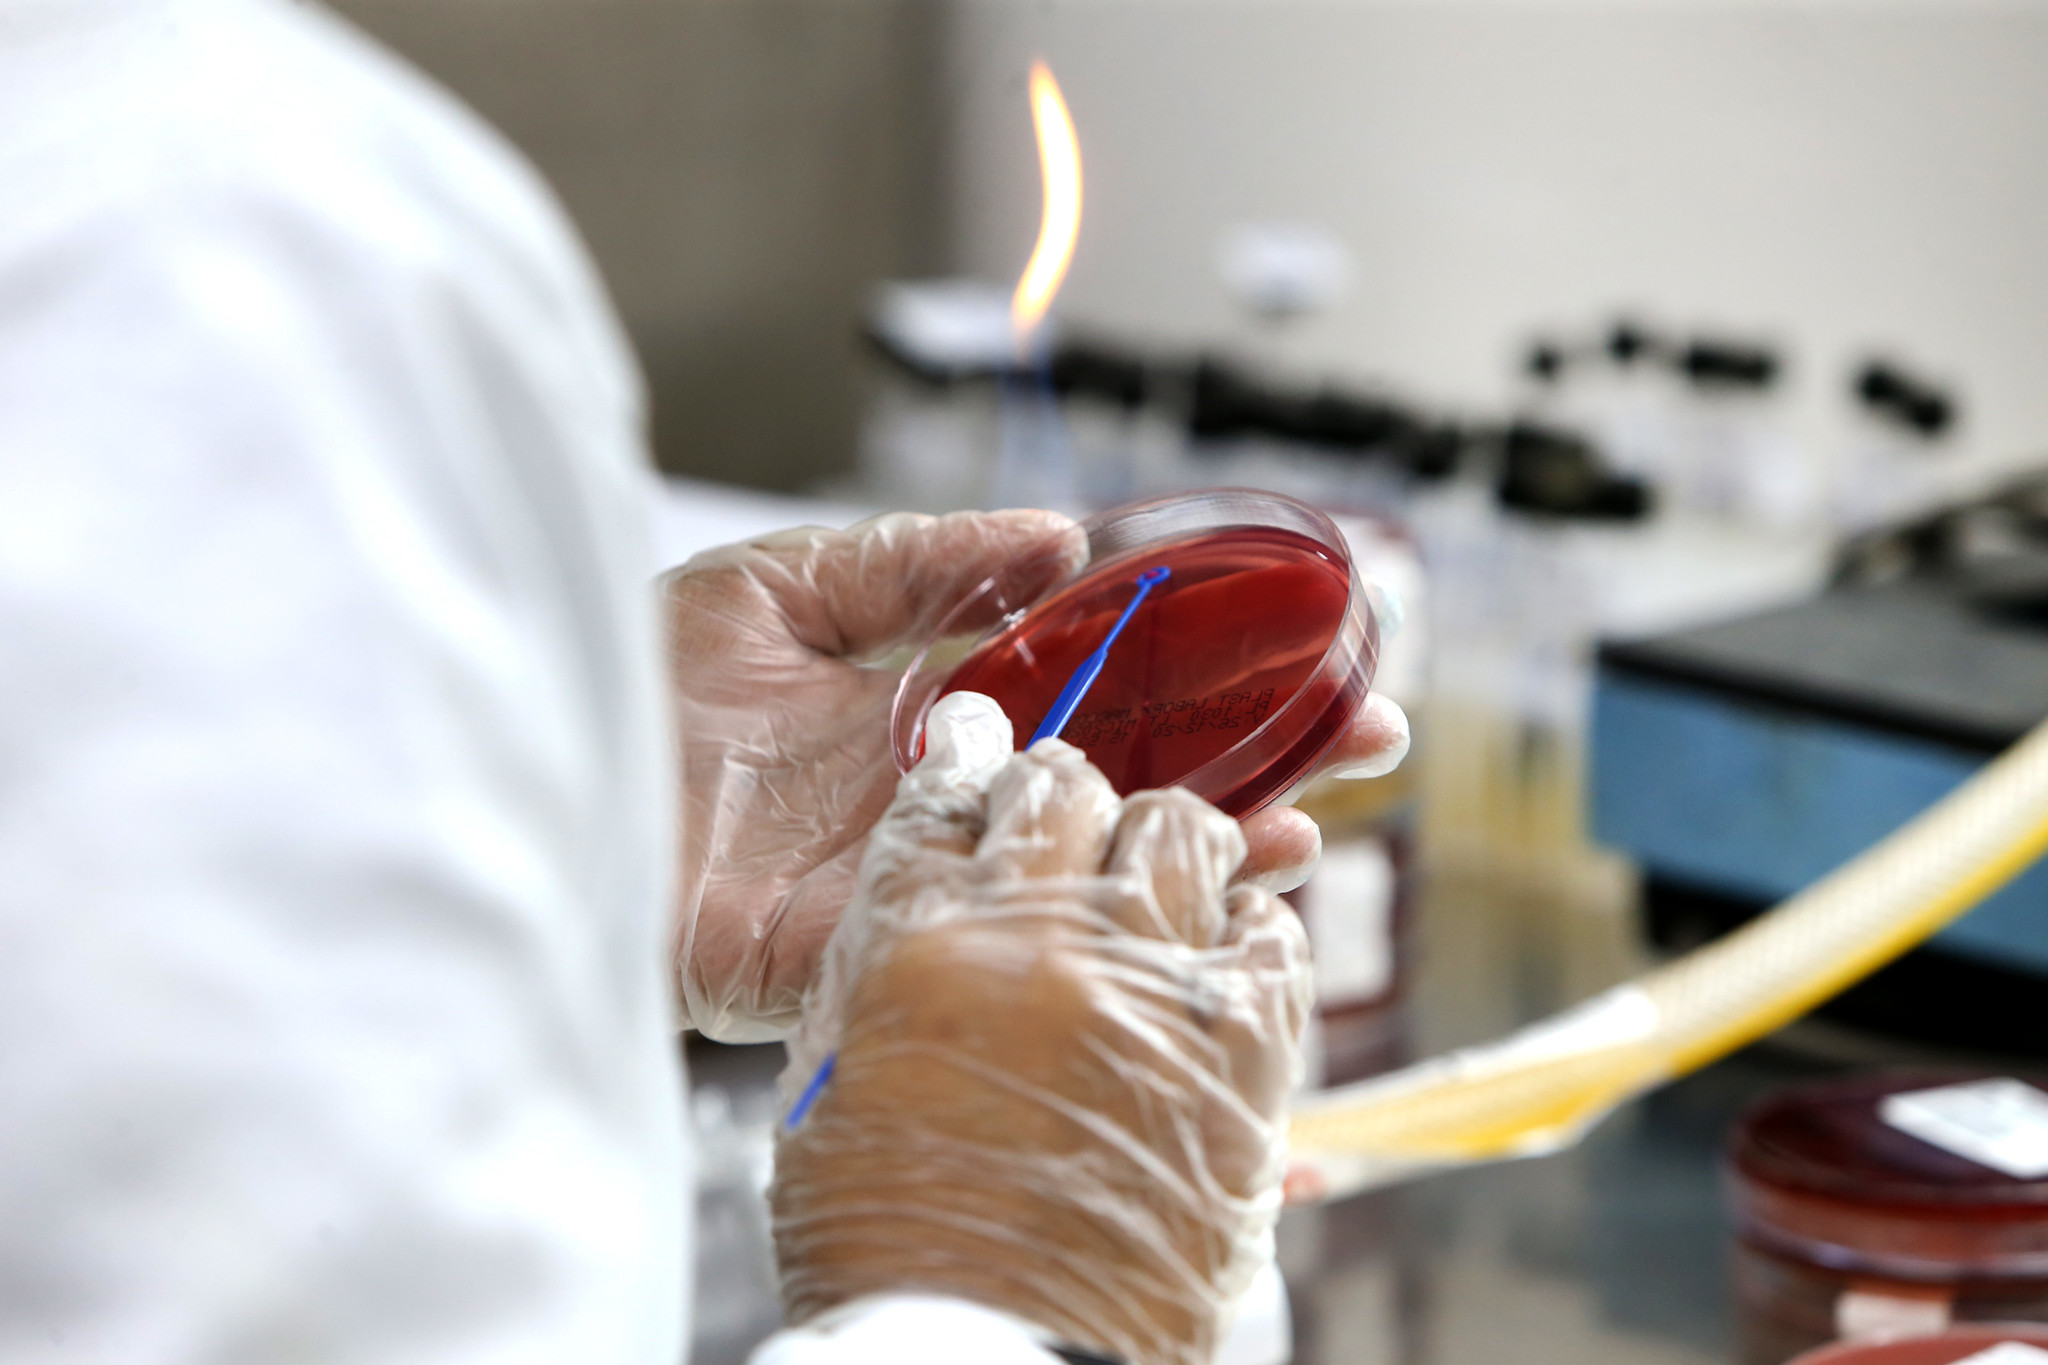

Doenças contagiosas como tuberculose, hanseníase, chagas, entre outras. A água contaminada, o alimento que não tem condições de ser consumido, o produto de limpeza que causa intoxicação. Para identificar tudo isso e muito mais, os 417 municípios baianos contam com o Laboratório Central de Saúde Pública Professor Gonçalo Moniz (Lacen-BA), que completa 105 anos de funcionamento na próxima segunda-feira (7), dia da Independência do Brasil. Este ano, o Lacen foi ampliado e tornou-se o maior laboratório público do país em capacidade para testagem da Covid-19.
Somente do coronavírus, a unidade já realizou mais de 268 mil testes, até esta sexta-feira (4). Com a ampliação, a capacidade do Lacen subiu de 400 para 4 mil testes por dia, com 85% dos resultados sendo entregues em até 48 horas. De acordo com o secretário da Saúde do Estado, Fábio Vilas-Boas, o investimento superior a R$ 2 milhões, em obras e equipamentos, foi planejado em janeiro, no início da pandemia.

“A ampliação compreendeu a construção de um pavilhão, ampliação do laboratório de biologia molecular, aquisição de novos equipamentos e contratação de insumos. Isso alçou o Lacen da Bahia ao principal laboratório público estadual do Brasil na capacidade de realizar exames para coronavírus”, afirma o secretário.
A diretora-geral do Lacen, Arabela Leal, destaca que todo o investimento feito na ampliação do Lacen por causa da Covid-19 vai continuar beneficiando os baianos mesmo depois que a pandemia estiver controlada. “Esta estrutura foi montada para a Bahia. O nosso laboratório de saúde pública está estruturado para o que vier. Temos também um projeto para a implantação do laboratório com nível de segurança 3, que nós ainda não temos”.

Funcionamento 24 horas
Segundo a diretora-geral, com a pandemia, a unidade passou a funcionar com uma estrutura de emergência. “Os exames da Covid-19 precisam sair em grande volume e rapidamente, para darmos a resposta que a população precisa. Nós passamos a trabalhar 24 horas, 7 dias por semana”. As outras atividades continuam sendo realizadas normalmente. Na parte superior da nova ala, está montado um laboratório de vigilância sanitária, que faz análises químicas de água, alimentos, produtos de limpeza, entre outros.
Por ser um Laboratório de Saúde Pública, o Lacen está relacionado às vigilâncias Sanitária, Epidemiológica e à Saúde do Trabalhador, explica Arabela Leal. “E nós atuamos de forma transversal, fazendo a análise dos dados. Quando a vigilância sanitária de algum município faz a apreensão de algum produto ou alimento, ou quando há a suspeita de um surto, todo esse material vem para o Lacen. Então, esta é uma ação conjunta de vigilância. Nós atuamos durante todo o ano, em parceria com as unidades sentinelas do Estado e dos municípios, que nos enviam as amostras”.
Funcionário da prefeitura de Bonito, na Chapada Diamantina, Ronie Oliveira é o encarregado de trazer o material coletado no município para ser analisado no Lacen. “Cinco vezes por semana, a gente vem trazer o material dos moradores para o diagnóstico do coronavírus. O atendimento é ótimo, rápido e eficaz. Não temos nada para reclamar”, comenta.
Prata da casa
Uma das mais antigas da unidade, a funcionária Ivete Sacramento está há 35 anos no Lacen. “Neste tempo todo, o Lacen melhorou muito. Aqui na bacteriologia, temos equipamentos novos. A gente consegue receber a bactéria pela manhã, coloca no aparelho e já tem o resultado à tarde. Também vi ser construído este novo prédio, que proporcionou mais espaço, com equipamentos modernos. É uma evolução mesmo”.
No total, o Lacen possui 360 funcionários atuando nos três turnos. “Além disso, nós estamos também com o Laboratório Municipal de Referência Regional, em Jequié, contamos com unidades em Porto Seguro, Paulo Afonso, Vitória da Conquista e ainda temos parceria com duas universidades, em Barreiras, no oeste, e Ilhéus, no sul da Bahia. Além disso, temos a Rede Estadual de Laboratórios de Saúde Pública [Relsp], que conta com a parceria com 12 municípios, e a Rede Estadual de Laboratórios da Qualidade da Água, com mais 12 municípios também”, detalha Arabela Leal.
Fonte: Secom | Fotos: Camila Souza